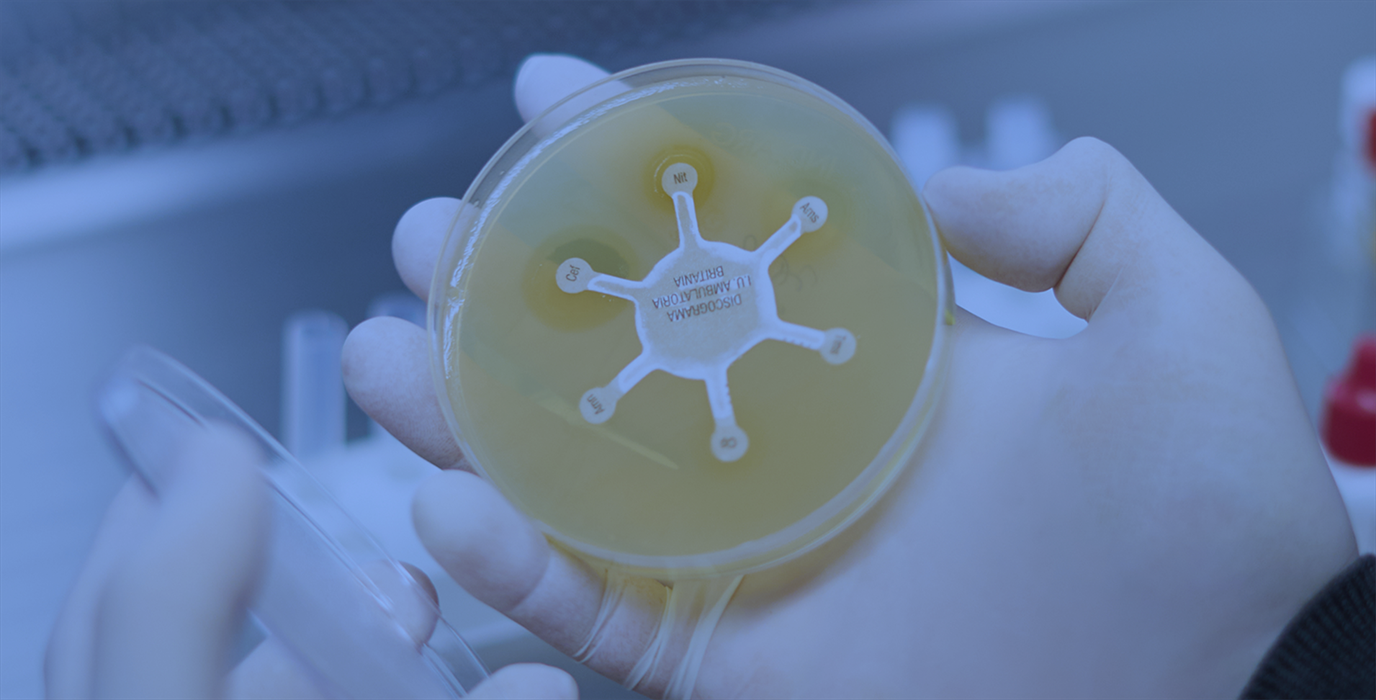

MÁS DE 50 AÑOS
cuidando tu salud
Dedicación y capacitación
continua para brindar
diagnósticos confiables

MÁS DE 50 AÑOS
cuidando tu salud
Dedicación y capacitación continua para brindar diagnósticos confiables
En Laboratorio Alaniz trabajamos desde hace más de 50 años con un mismo compromiso: brindar análisis clínicos con precisión, calidad y calidez humana.
Creemos que la confianza se construye con trayectoria, tecnología y un equipo que acompaña cada resultado.
En Laboratorio Alaniz trabajamos desde hace más de 50 años con un mismo compromiso: brindar análisis clínicos con precisión, calidad y calidez humana.
Creemos que la confianza se construye con trayectoria, tecnología y un equipo que acompaña cada resultado.
Cada resultado que entregamos se sostiene en tres pilares:
Cada resultado que entregamos se sostiene en tres pilares:
Tecnología de
última generación
altamente capacitados
acreditaciones de calidad
garantizan que cada análisis cumpla con los más altos
estándares de seguridad y fidelidad.
Contamos con certificaciones PAL y PEEC, que garantizan que cada análisis cumpla con los más altos estándares de seguridad y fidelidad.
Trabajamos con
más de 200 obras
sociales y prepagas.
Escribinos para consultar
por tu cobertura.
Trabajamos con
más de 200 obras
sociales y prepagas.
Escribinos para consultar
por tu cobertura.
Trabajamos con
más de 200 obras
sociales y prepagas.
Escribinos para consultar
por tu cobertura.
Todos los análisis, en un solo lugar
Hemograma
completo
Análisis de orina
Perfil lipídico
glicosilada
Estudios
hormonales
Cultivos
microbiológicos
Marcadores
tumorales
Chequeos
generales
EXCELENTE A base de 19 reseñas Publicado en Patricio Hondagneu RoigTrustindex verifica que la fuente original de la reseña sea Google. Siempre una experiencia de diez puntos en este laboratorio.Publicado en Pablo PardalTrustindex verifica que la fuente original de la reseña sea Google. Atención muy familiar y agradable. Uno se siente acompañado. Gracias 🙂Publicado en Mabel AbalTrustindex verifica que la fuente original de la reseña sea Google. Excelente atención muy amables desde que entras hasta que salis, siempre una sonrisa y eficacia en las prácticas!Publicado en Naty RiosTrustindex verifica que la fuente original de la reseña sea Google. Gracias por su cálida atención y rapidez! Súper compresivos y buena ondaPublicado en Graciela DaragonaTrustindex verifica que la fuente original de la reseña sea Google. ExcelentePublicado en Carolina BrunoTrustindex verifica que la fuente original de la reseña sea Google. Excelente atenciónPublicado en julieta ramirez borgaTrustindex verifica que la fuente original de la reseña sea Google. Excelente atención, rapidez y eficiencia. Sinónimo de tranquilidad para encarar cualquier estudio. Gracias!
Tu salud en las
mejores manos
Te esperamos en nuestras
sedes de Lunes a Sábados.
Te esperamos en nuestras sedes de Lunes a Sábados.
ESCRIBINOS POR WHATSAPP
-
Calle 38 #761 e/ 10 y 11,
La Plata, Buenos Aires - (221) 482-5882
-
Calle 45 #939 e/13 y 14,
La Plata, Buenos Aires. - (221) 483-6527
-
Calle 38 #761 e/ 10 y 11,
La Plata, Buenos Aires - (221) 482-5882
-
Calle 45 #939 e/13 y 14,
La Plata, Buenos Aires. - (221) 483-6527
- Calle 38 #761 e/ 10 y 11, La Plata, Buenos Aires
- (221) 482-5882
- Calle 45 #939 e/13 y 14, La Plata, Buenos Aires.
- (221) 483-6527
